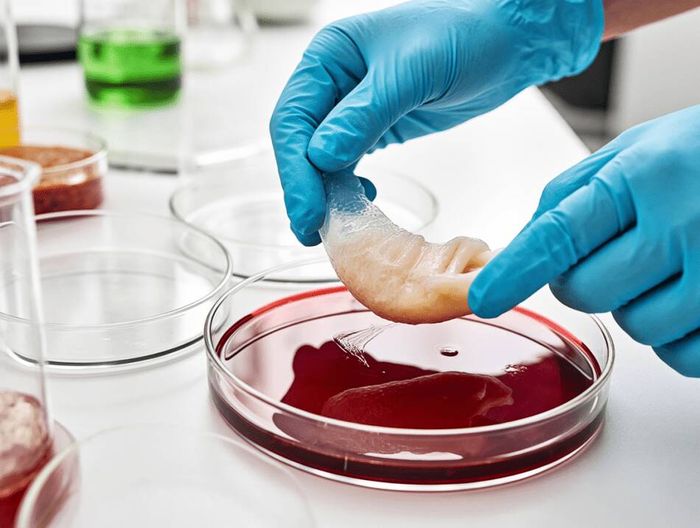
医用手套生物相容性检测

生物相容性检测服务
在医疗器械检测领域,生物相容性检测指通过细胞毒性、致敏、刺激等试验,评估材料与人体接触时的安全性,考察是否引发炎症、过敏等反应,是确保器械临床使用安全的关键检测。
其核心是依据相关标准,验证材料与人体组织的相容性,降低不良反应风险,为医疗器械的生物安全性评价提供科学依据。
该服务由【微析技术研究院下属[生物相容性检测]】专项实验室承接。
服务客户
+
出具报告
+
专业人员
+
实验仪器
+
微析服务优势
SERVICE ADVANTAGES

CMA/CNAS资质
微析技术研究院已经过严格的审核程序,同时获得了CMA/CNAS双资质认证,是一家专业正规的三方检测中心。

数据严谨精准
提供精准的数据支持,建立了完善的数据管理系统,对每个检测项目数据进行详细记录与归档,以便随时查阅追溯。

独立公正立场
严格按照法律法规和行业标准行事,不受任何外部干扰,真实反映实际情况,出具的检测报告具有权威性和公信力。

服务领域广泛
服务领域广泛,涉及众多行业。食品、环境、医药、化工、建筑、电子、机械等领域,都能提供专业检测服务。
检测服务流程
SERVICE PROCESS
只需四步
轻松解决需求

1、确定需求
欢迎来公司实验室考察,或与工程师电话沟通业务需求

2、寄送样品
微析院所工程师上门取样或自寄送样品到微析指定院所

3、分析检测
样品分析/检测,技术工程师开始制作分析汇总报告

4、出具报告
寄送报告,工程师主动售后回访,解决您的售后疑惑
关于微析院所
ABOUT US WEIXI
微析研究所总部位于北京,拥有数家国内检测、检验(监理)、认证、研发中心,1家欧洲(荷兰)检验、检测、认证机构,以及19家国内分支机构。微析研究所拥有35000+平方米检测实验室,超过2000人的技术服务团队。
业务领域覆盖全国,专注为高分子材料、金属、半导体、汽车、医疗器械等行业提供大型仪器测试(光谱、能谱、质谱、色谱、核磁、元素、离子等测试服务)、性能测试、成分检测等服务;致力于化学材料、生物医药、医疗器械、半导体材料、新能源、汽车等领域的专业研究,为相关企事业单位提供专业的技术服务。
微析研究所是先进材料科学、环境环保、生物医药研发及CMC药学研究、一般消费品质量服务、化妆品研究服务、工业品服务和工程质量保证服务的全球检验检测认证 (TIC)服务提供者。微析研究所提供超过25万种分析方法的组合,为客户实现产品或组织的安全性、合规性、适用性以及持续性的综合检测评价服务。

十多年的专业技术积累

服务众多客户解决技术难题

每年出具十余万+份报告

2500+名专业技术人员